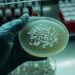
Brote de fiebre tifoidea en Ciudadela: ya son 15 los casos confirmados

La fecha tiene como objetivo generar conciencia sobre esta problemática que afecta a millones de niños y adolescentes en el mundo, causa aproximadamente 200 muertes al año y requiere de la mirada atenta de toda la comunidad.
El 2 de mayo se celebra el “Día Mundial Contra el Acoso Escolar” conocido también como “Bullying”. La propuesta de instalar esta fecha en el calendario surgió de ONG Bullying Sin Fronteras y fue aprobada por la UNESCO en 2013; y avalada luego por el senado argentino. Desde la ONG explican que “el bullying es un enemigo silencioso que se nutre de tres venenos: la soledad, la tristeza, el miedo”.
Qué es el acoso escolar
El bullying es definido como la injustica o abuso de poder que sufren los alumnos en las aulas.
Según Unicef, el “bullying” es una forma de violencia entre dos personas (estudiantes) en el ambiente educativo. Es una forma de discriminación de unos estudiantes hacia otro u otros por sus características o su forma de ser: orientación sexual, identidad de género, nacionalidad, situación migratoria, etnia, sexo, condición socioeconómica, condición de salud, discapacidad, creencias religiosas, opiniones, prácticas basadas en estigmas sociales, embarazo, entre otras.
Un informe de UNICEF Argentina revela que 3 de cada 10 niñas, niños y adolescentes son víctimas de acoso escolar y 7 de cada 10 han presenciado situaciones de violencias en los entornos escolares. La agencia de Naciones Unidas ofrece una guía para prevenir el acoso escolar.
Los niños o jóvenes que sufren acoso escolar por parte de otros estudiantes o son testigos de situaciones de violencia de forma reiterada tienen un menor rendimiento académico a corto y a largo plazo.
Esta situación puede acentuarse a lo largo del tiempo y provocar en la persona afectada una depresión que puede llevarla a no asistir a clase y dejar los estudios.
Sin embargo, además del impacto personal, el bullying afecta a toda la comunidad, tiene consecuencias negativas en el bienestar, el desarrollo y el ejercicio de los derechos de los niños, niñas y adolescentes. Por eso el Estado tiene la responsabilidad de prevenir y abordar esta problemática y promover una vida libre de violencias.
La profesora Soledad Fuster, especializada en la temática lo explica así: “Cuando hablamos de bullying nos estamos refiriendo a una agresión sistemática, sostenida en el tiempo, de una misma persona agresora o grupo hacia una misma víctima. En general comienza con una violencia psicológica, en apariencia sutil, a través humillaciones, burlas, insultos, amenazas, que se va complementando con actos de violencia física, como por ejemplo, hacer tropezar a la víctima cuando pasa, pegarle o empujarlo; colocar pegamento en el banco, esconderle los útiles, romper sus pertenencias, reírse ante sus preguntas o participación en clase, entre otros.”
Para Fuster hoy, “no podemos hablar ya casi del bullying sin pensar en el ciberbullying porque todo lo que pasa en la vida de los chicos y las chicas hoy está atravesado por lo digital”.
“Si están ejerciendo violencia contra un chico o una chica inevitablemente en algún momento lo van a subir a las redes, van a mandar fotos por chat, lo van a excluir de los grupos de WhatsApp, etc. El ciberbullying está en línea directa con el bullying, incrementando el padecimiento de la víctima”, explica la licenciada en Psicología.
Qué podemos hacer
Para hacer frente a esta problemática es muy importante saber detectar las señales. Si los niños están desanimados, tristes, con miedo y les cuesta ir al colegio, puede que estén siendo víctimas del acoso. Y también es necesario que las familias estén atentas a observar si sus chicos están ejerciendo violencia sobre otros o siendo testigos silenciosos de estas conductas.
Siempre es bueno abrirse a la escucha y conversación. El respeto es el primer paso para abordar estas situaciones y colaborar en su solución. Y ante cualquier caso tomar medidas preventivas inmediatas, recurrir a las instituciones.
Existen tres prácticas negativas a las que recurren los adultos y que no facilitan a las víctimas poder expresar lo que les pasa:
Micromachismos: la víctima recibe comentarios como “se tiene que hacer hombre”, “llora, parece una nena”.
Adultocentrismo: se trata de interpretar el padecimiento de un chico o una chica víctima como un evento poco significativo, entendiendo desde una mirada adultocéntrica que los problemas verdaderamente graves, son aquellos que atraviesan las personas adultas. Estas situaciones se expresan mediante frases como “son cosas de chicos, ya las van a resolver”, “no les des importancia”, “sentate en otro lado”, “tenés que hacerte fuerte, hacete respetar”
Corresponsabilidad: además del chico o la chica que ejerce la agresión, están quienes participan activamente, acompañando, incentivando y/o filmando lo que ocurre y aquellos/as que observan en silencio sin intentar detener a quien agrede. De este modo, refuerzan el poder que el chico o la chica agresora siente tener y habilitan que la violencia contra la víctima continúe, incrementando su padecimiento.
Muchas personas aún creen que el bullying se da cuando un chico no puede defenderse de las agresiones. Sin embargo, lo que ocurre es que la víctima intenta defenderse y pedir ayuda, lo hace de la manera que puede, pero se encuentra con que nadie está dispuesto a brindar protección.
Otro malentendido es que a veces las personas adultas, por desconocimiento, creen que el acoso escolar es solo violencia física, lo que cuando ocurre se conoce como ‘estallido’. Los estallidos son los que aparecen después de un tiempo de agresión -en apariencia- silenciosa, donde quizás la violencia física no estuvo presente, pero sí la psicológica y emocional, que en muchas oportunidades no es percibida por docentes ni familiares.
Por eso, es importante trabajar con el chico o la chica víctima, afectado por la violencia recibida brindando protección, contención y asistencia psicológica si lo requiriera, y también con quien cometió la agresión.
La víctima de bullying a veces puede poner en palabras lo que le está pasando y otras no. Sin embargo hay indicadores a través de cambios conductuales o emocionales y de distintas maneras como:
- No quiere ir al colegio o se empieza a sentir mal antes de ir
- Vuelve del colegio con hambre (porque le sacaron la comida)
- Vuelve del colegio con golpes o cosas rotas
- Empieza a perder la concentración en el colegio, baja sus calificaciones
- Empieza a estar desganado, pierde interés por actividades de las que antes disfrutaba
- Se muestra más angustiado, sensible o enojado
- Se aísla
- Busca la protección de adultos en situaciones donde hay otros chicos presentes
- Evidencia alteraciones en el sueño o la alimentación
- Tiene pesadillas
- Se autolesiona
Por otra parte, los especialistas destacan que prevenir la violencia en la escuela resulta más difícil si las figuras públicas naturalizan la violencia como forma de expresión, ya que esto echa por tierra el trabajo que se hace en las instituciones para que los chicos sean más empáticos y puedan detectar y frenar las situaciones de acoso.

Unesco. Juntos contra el acoso escolar
MP – elDiarioAR